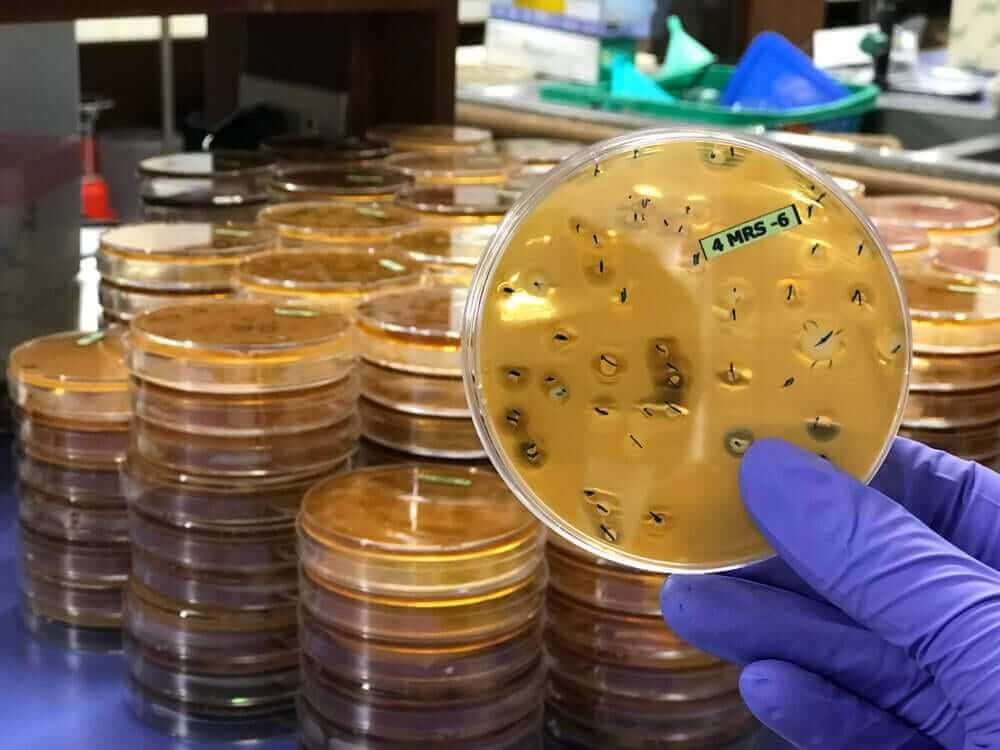

The equine digestive microbiome has become an area of interest in recent research, attempting to determine if connections exist with other health and lameness concerns. In human research, a large amount of data has been produced regarding the health of the digestive microbiome and implications on overall health and quality of life in the individual. The microbiome is essentially an organ system, composed of hundreds of species of bacteria, protozoa, and fungal organisms that play a direct role in digestion of food, but also play a major role in cellular signaling, cognitive function, and inflammation. When this microbiome is out of balance, problems can quickly develop and can be life threatening on many levels. Ultimately, considering the vastness of the equine digestive microbiome and potential connections with conditions ranging from metabolic concerns, to laminitis, joint health, emotional disturbances, and digestive upset, functional solutions are being investigated.
Introduction

The digestive microbiome is extensive in the horse and is comprised of specific organisms inhabiting certain areas of the intestinal tract. One area of focus is on hind-gut health, and the influence of the microflora in this region on overall health and digestion. In human research, data has been collected through hundreds of research papers and the final conclusion is that the microbiome does appear to be connected with overall health, but could also be tightly linked in with cardiovascular disease, metabolic conditions, diabetes, allergies, cognitive function, digestive concerns (IBS, IBD), joint degeneration, and cancer. (1) The ultimate question remains as to whether these same associations can be made in the horse.
The term dysbiosis is used to reflect a state of imbalance within a microbiome, specifically as it pertains to this paper, it would be the gastrointestinal microbiome. Indeed, there are many microbiomes that exist in the body, from the skin, to the ears, and the urogenital tract. Various organisms essentially live in harmony, a state of symbiosis, in which health is provided to the individual horse. When these organisms become unbalanced, due to a variety of factors, a state of disease can be produced.
Considering the large number of organisms present, human researchers have narrowed down the groups based on originating phlya, focusing on two groups in particular; Firmicutes and Bacteriodetes. There are numerous bacterial organisms that reside under each of these subheadings. What is noted in research and appears to be a trend, is that when the Firmicutes group outnumbers the Bacteriodetes population, then a person and potentially a horse is more at risk of disease. Essentially, this dysbiosis can be considered a risk factor for various health ailments. In the ideal situation, one may desire to have the two groups more in balance, but it is not possible to have precise numbers as these populations are always in a state of flux to a degree. Commonly referenced bacteria to these two phyla include Lactobacillus (Firmicutes) and Bifidobacteria (Bacteriodetes), which both are used as probiotics in human health.
Equine research regarding the microbiome is not as voluminous as their human counterparts, although more studies are being published. In past studies, evaluating metabolic and laminitic equine patients, it has been noted that there appears to be an overgrowth of lactic acid bacteria, predominantly Streptococcus species, which is found in the Firmicutes group. (2) As this lactic acid bacteria count increases, the Firmicutes group would become more representative than the Bacteriodetes, and thus imbalance would occur. In other studies, regarding colitis and diarrhea in the horse and foal, there are papers that denote overgrowth of pathogenic organisms including Salmonella, Escherichia coli, and Clostridial organisms, which are often linked back with endotoxic conditions in the horse. In many of these clinical cases, there is an overall reduction in richness or diversity to the microbial population. (3,4) These bacteria are often considered a normal part of the equine digestive tract, but usually are in low numbers. In theory, if there is imbalance in one direction or another, this would not only impact digestion, but could also alter the gastrointestinal environment, making it more favorable for some bacteria and less so for others. As a result, if the environmental changes were significant enough, more pathogenic bacteria could increase in numbers and create direct clinical harm to the patient.
The precise means as to how these imbalances in the microflora contribute to disease are not readily known. In many research papers, there are many concepts theorized. Digestion can be impaired, including nutrient absorption, and therefore impact overall health of the host. Production of short chain fatty acids can also be impaired, which contributes to overall health and inflammatory status. The environmental changes and alterations in the local pH could also contribute to increased permeability of the intestinal lining, leaky gut, which can lead to increased release of bacteria and other chemicals found in various foods, into the systemic circulation. As a result, this can lead to a heightened level of inflammation in the patient often as a result of the immune response and lipopolysaccharide (LPS) release, which can contribute to a host of chronic inflammatory and degenerative conditions.
The one challenge that presents itself is resolving or at least providing a better means of management of this ongoing problem regarding dysbiosis in the gastrointestinal microbiome. Looking at the problem, the exact cause has yet to emerge. Instead of one specific cause, it is more likely to be multifactorial in its origin, which further complicates a solution.
In many human research papers, various options have been utilized, which all seem to provide some level of benefit. These include stress reduction, exercise, prebiotics, and probiotics. The foods that are consumed and the stress levels that are placed upon the person or animal appear to be most connected with the microbiome and overall balance. However, placing just one solution or remedy into place does provide improvements in some, but not all research subjects. The use of probiotics in human patients does appear to provide benefits, but this research is lacking in the horse. In theory, the use of the most prevalent strains of probiotics in the horse industry, Lactobacillus, could potentially push the dysbiosis in the opposite connection, contributing more to overgrowth of the Firmicutes group. Outside of probiotics, at least in the horse, we are often left with managing the impact of stress and utilizing prebiotics, ideally in the form of whole foods. There are isolated prebiotics on the market, including Inulin and fructooligosaccharides (FOS) or their derivatives MOS or XOS. However, despite some promising research, one has to keep in mind that these molecules could have the potential in high doses of pushing the spectrum to the other degree and creating clinical harm, as they are used as a food source for all bacterial species. This is noted in laminitis research papers in using FOS in high doses to create laminitic conditions.
The ideal solution to the current dilemma would be to have an all natural, non-harmful solution to better promote healthy bacteria within the gastrointestinal tract of the horse, hinder the growth of more pathogenic organisms, and potentially normalize the overall environment in the digestive tract. This solution or option would also infer local and systemic inflammatory protection and potentially impact the stress process.
Methodology
A total of 16 horses were recruited for this trial, being non-selective in the breed, age, gender, or presenting condition. A total of 150 prior horses had been cultured in the past 2 years to evaluate overall trends of lactic acid bacteria (LAB), Coliforms, and more recently Salmonella levels in the perceived normal horse. The term ‘normal’ is relative and precise levels can be difficult to determine, as many horses do have health issues, but not to the level of concern to the owner. Current or existing diet and/or supplementation regimens with each patient was not altered, allowing the patient to continue as currently being managed.
Each horse was placed on a proprietary blend of a patented, concentrated extract of Terminalia chebula, Terminalia bellerica, Phyllanthus emblica, and Humulus lupulus 4:1 extract. The average dose per patient per day, of the proprietary blend, was 7.75 grams /1000 lbs (500kg), given once daily. The supplement was well accepted in most patients and flavored with a whole-organic banana powder.
Fecal samples were collected on day one and fourteen in all patients. The samples were collected and contained in plastic bags, left open to allow for air circulation and prohibition of an anaerobic environment.
The cultures were performed by obtaining 1 gram of fecal material from the center of a provided fecal ball, and diluting it out to a 1:10,000 dilution using sterile saline. Then 1.0 ml of fluid was inoculated onto 3M Lactic Acid Bacteria Petrifilm, 3M Coliform Petrifilm, and 3M Salmonella Petrifilm plates, then incubated for 18-24 at 35 degrees C. Colonies on each plate were then counted and recorded. Counts in excess of 500, were approximated or given the value of TNTC (too numerous to count).
Results
All 16 horses involved in this current trial demonstrated improvement with measurable reduction in lactic acid bacteria counts on follow up cultures. Each horse also demonstrated improvement clinically on some level, ranging from attitude to overall soundness.

Discussion
The gastrointestinal microbiome in the horse is vast and can be considered an organ system by itself, due to the involvement and connection with other aspects of health and cellular signaling in the body. A dysbiosis or imbalance of the microbiome can potentially impact horse health and soundness negatively, contributing to metabolic and laminitic conditions, allergies, colitis (endotoxemia), digestive upset with gas or recurrent colic, ulcerative conditions, body and hoof condition, and athletic performance.
Despite the current research to date and solutions offered in the horse, there are a large percentage of horses that continue to battle the effects of poor digestive health, ulcers, and overall impact on general health. Modern research indicates that a dysbiosis does indeed exist in the horse, given a variety of conditions, but mainly focusing on laminitic and metabolic patients. Even with this information, we can see the problem but have yet to arrive at a reasonable solution.
Human research has indicated that several environmental, physical, and lifestyle factors are involved with the development of a dysbiosis situation within the gastrointestinal tract. Given the large number of factors, arriving at one solution is not likely feasible, but could at least benefit some patients on some level.
The herbs utilized in the proprietary blend are not new to science or the history of the horse. The three herbs, Terminalia chebula, Terminalia bellerica, and Phyllanthus emblica have traditionally been used together in an Ayurvedic formula called Triphala. This formula has been used likely for centuries to promote overall digestive health and specifically in other conditions involving the mouth, skin, and other organ systems. These three herbs have marked potential based on research data, noting marked anti-inflammatory properties, antioxidant potential, prebiotic benefits, anti-microbial benefits, and laxative type benefits. The herbs have many beneficial phytochemicals present, including antioxidants, flavanoids, and a rich base of Tannins. These fruits have also been shown to contain starches, amino acids and fatty acids. (5)
In the original Triphala herbal blend, the whole fruit extracts have been utilized, however in our preliminary research trials, many horses failed to demonstrate benefits on repeat cultures. This may be attributed to a dose effect and also could be reflective of the level of inflammatory damage within that patient. The concentrated, patented version of each fruit was utilized in this current study, which helped to reduce overall dosage to the patient and likewise produced clinical benefit. The concentrated extracts provide in general >50% soluble tannins, which is one of the main active ingredients, but also contains smaller levels of the above mentioned phytochemicals.
Humulus lupulus, Hops, has been used traditionally in the horse as a aid in resolving various health conditions including digestive upset and colic. Hops is also a primary ingredient in the making of beer, not just to enhance flavor but to mitigate the growth of lactic acid bacteria, which results in spoilage. Research in the horse regarding Humulus lupulus notes that it can impact the overgrowth and survival of Streptococcus species of bacteria in laminitic patients, which contributes to overgrowth of lactic acid bacteria. (6) Humulus lupulus is a polyphenol rich food group that has demonstrated abilities to modulate inflammation, enhance digestion and body weight gains in pigs, and contain anti-microbial properties. (7)
The combination and utilization of all 4 ingredients in the proprietary research formula provides many clinical benefits to the horse, including prebioitic, probiotic, and anti-microbial properties. In addition, Terminalia chebula, Terminalia bellerica, Phyllanthus emblica, and Humulus lupulus demonstrate marked anti-inflammatory and antioxidant properties which can benefit the horse on many levels, even outside of the gastrointestinal tract.
Based on numerous prior cultures of perceived normal equine patients, a normal value on lactic acid bacteria levels with this specific culture technique was assigned a value of <150 colonies. Coliform counts in the normal population averaged around 25-50 colonies.
In this study, all 16 horses responded favorably with a reduction in lactic acid bacterial levels on follow up cultures. Interestingly, many of the patients were evaluated for levels of Coliforms and Salmonella, which became available in a later part of the study. Many of the horses demonstrated a marked increased in Coliform levels, including Escherichia coli, on initial cultures. Salmonella was undetectable in all patients. As the lactic acid bacteria level decreased on follow up, it was also noted that in most horses, the Coliform count likewise reduced. This could be a favorable indicator for reduced susceptibility to colitis conditions and endotoxic events.
There were no noted side effects in any horse during the 14 day trial period. Grossly, fecal samples began to take on a more green color with increased moisture content, less odor, and less dense fibrous roughage evident in the sample. These changes are likely attributed to the prebiotic effect and alteration of the gastrointestinal microbiome, indicating improved digestion which would then equate to improved nutrient utilization by the horse.
All owners noted a positive change on some level in a short period of time. There were improvements in overall soundness with reduction of foot pain and improved comfort in a few laminitic horses. Many owners noted the reduction in fecal odor and/or gas production in their horse. Some owners also noted changes in hoof growth and increased rate of sole exfoliation. In another patient, allergies appeared to be improved with reduction of skin lesions and itching. Other changes include improved behavior, energy, and estrus cycles.
Although each horse demonstrated clinical benefits during the research period, some horses reduced their counts further than other horses, more towards a perceived ‘normal’ level. The ultimate question is regarding why the difference and could more impact be accomplished with a lower LAB count? There are several factors to keep in mind when evaluating the results and situation for any given equine patient. First, diet is a major contributor as noted in human studies. Many of these horses were maintained on their current diet of processed grains or feed products, which could interfere with microbial balance. Second, there is the potential for medication influences on the microbiome and a few of these patients were on a thyroid and/or Pergolide medication daily. Third, there are environmental factors including housing, herd dynamics and exercise limitations which may also play a role. Fourth, one has to keep in mind the level of inflammation and the chronicity in each patient. In a case of laminitis due to metabolic syndrome, as an example, one needs to understand the vastness of the inflammatory process in that animal and the level of damage that has been created over time. The microbiome is likely a major player in this health condition in the horse, but even with stabilization, time is required for further systemic inflammatory changes, tissue healing, and hoof regrowth. In the end, progress was made and demonstrated in each patient, but for some more time may be required to fully benefit from the alterations in the microbiome. It is also very possible that the anti-inflammatory effects of the herbs utilized in the proprietary blend may reach far beyond the gastrointestinal tract, which can further add benefit to the patient, even potentially impacting the metabolic status and sugar metabolism. This has been noted in human research. (10)
Conclusion
The gastrointestinal microbiome is an organ system in itself, linked closely with overall health on many levels. When this system is out of balance, disease and a lack of health can quickly develop. Keeping the microbiome balanced to the best of our abilities is likely a major step in regaining equine health and even performance. Accomplishing this task may not be easy and likely involves a several stage process from the diet to stress management in any given horse. The proprietary blend utilized in this research trial does offer hope that gains can be made to re-balance the microbiome in the horse, reduce potentially pathogenic bacteria numbers, and offer anti-inflammatory benefits. This blend could provide much needed benefits on many levels to the average horse whether a high-level competitor or one suffering the pains of chronic laminitis.
Researcher Notation: The use of the Triphala blend with concentrated tannins (Cur-OST EQ Tri-GUT) has demonstrated similar benefits in further follow ups regarding the equine digestive microbiome and assisting in balance without the need for Humulus lupulus or yeast extracts. Custom digestive blends for the horse are available, including formulations with Humulus lupulus and other herbs, through Secondvet.
Author: Tom Schell, D.V.M., CVCH, CHN
Notes: Dr. Tom Schell is a chief researcher and product developer for Nouvelle Research, Inc., and also maintains active consultations to equine patients through Secondvet.
Author contact: tschelldvm@gmail.com
References:
- Tojo R et al. Intestinal microbiota in health and disease: Role of bifidobacteria in gut homeostasis. WJG, 2014, Nov 7;20(41):15163-15176
- Milinovich GJ, et al. Microbial ecology of the equine hindgut during oligo-fructose induced laminitis. ISME J, 2008, Nov; 2(11):1089-100
- Costa MC, et al. Comparison of the fecal microbiota of healthy horses and horses with colitis by high throughput sequencing of the V3-V5 region of the 16s rRNA gene. PLoS ONE, 2012, July: 7(7).
- Schoster A, et al. Comparison of the fecal bacterial microbiota of healthy and diarrheic foals at 2 and 4 weeks of life. BMC Vet Res. 2017, May 30;13(1):144
- Peterson CT, et al. Therapeutic Uses of Triphala in Ayuvedic Medicine. J Alt Comp Med. 2017, 23(8): 607-614.
- Harlow BE, et al. Inhibition of fructan-fermenting equine faecal bacteria and Streptococcus bovis by hops (Humulus lupulus) beta-acids. J Appl Micro. 2014. Aug;117(2):329-39.
- Fiesel A, et al. Effects of dietary polyphenol-rich plant products from grape or hop on pro-inflammatory gene expression in the intestine, nutrient digestibility and faecal microbiota of weaned pigs. BMC Vet Res. 2014, 10:196.
- Kishore K.K., et al. A study of terminalia chebula extract on endothelial dysfunction and biomarkers of oxidative stress in patients with metabolic syndrome. Eur J Biomed Pharm Sci. 2016, 3(2):181-88.
Is this a peer-reviewed and/or published paper? Or is this only based on the institution’s research alone?
This research data was not published but conducted out of our clinical trials in rehabilitation practice. Thank you.
I used 900 as a plug for TNTC and I am sure this is no more that mildly interesting. I have been interested in the importance of gut bacteria as I understand that they play a huge role in the digestion of structural carbohydrates. This would seem most important in winter months.
Before Average
average of small horses 658
average of QH 775
avg TB 700
avg all horses 692
After Average Delta
average of small horses 204 -454
average of QH 151 -624
avg TB 150 -550
avg all horses 184 -508
Standard Deviation Before
small 319
QH 250
TB 283
Standard Deviation After
small 72
QH 48
TB 35
Maybe I missed something but your current Tri-Gut formula, which I am currently using, does not have the Humulus lupulus or the Saccharomyces cerevesiae in it. What is the reasoning of now leaving it out? Also, on your website it still has those ingredients listed. Thank you!
Hi Lea, that’s a good question! In truth, what we found out in research outside of that project was that in 80% of the horses, the standard triphala blend with concentrated tannins, which is present in the current EQ Tri-GUT, was just as effective at modulating the digestive microbiome as the original 5 herb formula in the original study we conducted. The formula also became more cost effective for the average horse owner by reducing it down to just the concentrated Triphala blend. So, it was a win-win. Yes, thank you for noting the current product page. The label ingredients had been updated, but there was a technical glitch today that was preventing it from showing. It has been corrected. Thank you!
My two horses have fecal water syndrome. They are also located in two different areas. Will the Triphala blend help them one has had it since he six years old and the other acquired it since fall. Thank you very much.
Yes, the Cur-OST EQ TriGut can be very helpful in these cases. Here is an article on fecal water syndrome. https://nouvelleresearch.com/index.php/articles/38621-equine-fecal-water-syndrome-loose-stools